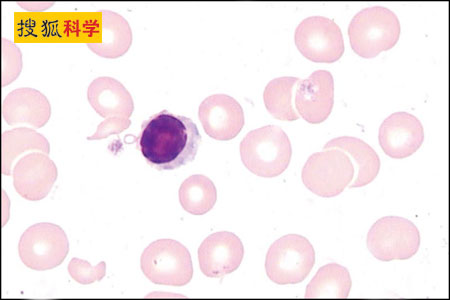

作者:尚力
无核红细胞
《新科学家》网站8月20日报道,美国科学家首次在实验室培育出人体无核红细胞,这意味着人类在人造血液的进程上又迈出非常重要的一步。在不久的将来,献血将成为历史。 普通人平均每200毫升血液中有2万亿个红细胞。红细胞的功能是运输氧、二氧化碳、电解质、葡萄糖以及氨基酸这些人体新陈代谢所必须的物质。因此,若要制成人造血液,科学家首先必须大批量培养出红细胞。美国生物科技集团先进细胞技术公司(Advanced Cell Technology)首席科学家、人胚胎干细胞克隆先驱罗伯特·兰萨(Robert Lanza)教授表示,他们已经在这一技术上取得重大突破,“以后人们就不用担心血液短缺的问题了。一旦这项技术成功的应用于实际生产,你想要多少血液就有多少”。 罗伯特·兰萨教授和他的合作伙伴首先从人体干细胞中提取营养物质和合成红细胞所必须的物质,然后将它们培养成血管原细胞(haemangioblasts),血管原细胞是血液红细胞形成之前的一种形态。最后研究人员将它们培养成成熟的红细胞。罗伯特·兰萨教授指出,虽然在此之前已经有科学家制造出红细胞,但是在很多关键问题上都没有取得突破,比如无法传递营养物质,或者无法形成代谢。但是他们这项技术在这些关键点上都取得了重大突破。实验结果证明,通过他们这项技术造出来的红细胞可以和人体体内的红细胞一样有效的传递氧气和营养物质,最重要的是这种人造红细胞是没有核的。罗伯特·兰萨教授说,“在此之前,许多专家认为人造红细胞去核是不可能的。但是,我们非常吃惊在这个问题上我们取得了突破”。 罗伯特·兰萨教授指出,成熟的红细胞必须是无核的,红色、呈双凹圆盘形、直径大约7~8微米,中央较薄,周边较厚。这种形态特点的生理意义在于使红细胞的可塑性增大,在通过管径微小的毛细血管和血窦时,能发生变形一挤而过,然后又恢复原状。另一方面,双凹盘形结构使细胞表面积增大,扩大与血浆之间的交换面积,提高气体交换效率。因此,要保证人造红细胞的活性,去核非常重要。运用这项技术,研究人员已经能够在实验室批量生产红细胞了,每次制造的红细胞可以达到1000亿个。 罗伯特·兰萨教授表示,他们的研究成果具有非常重要的意义。人造血液可以降低因接受捐赠者血液而感染疾病的风险,而且他们这项技术可以批量制造“万能血液”——O型血。整个白种人中只有8%的人是O型血,而亚洲人中O型血的比率则更低。不过,他也指出,制造O型血还需要攻克基因遗传这一关,因为人体的血液类型是由基因来决定的。但是目前在美国,对人体胚胎干细胞的基因进行研究还是不允许的,他们打算利用人体的皮肤细胞来进行相关研究。罗伯特·兰萨教授相信,他们这项技术在不久的将来一定会得到实际应用的,因为它必将造福全人类。 |